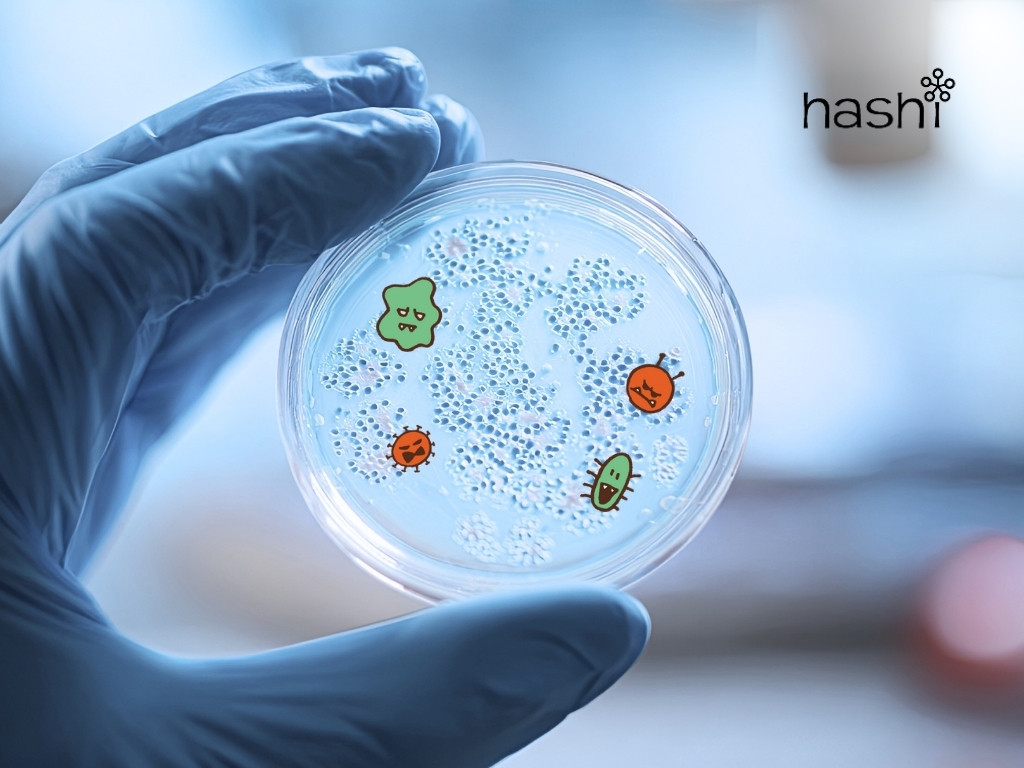
bacteria
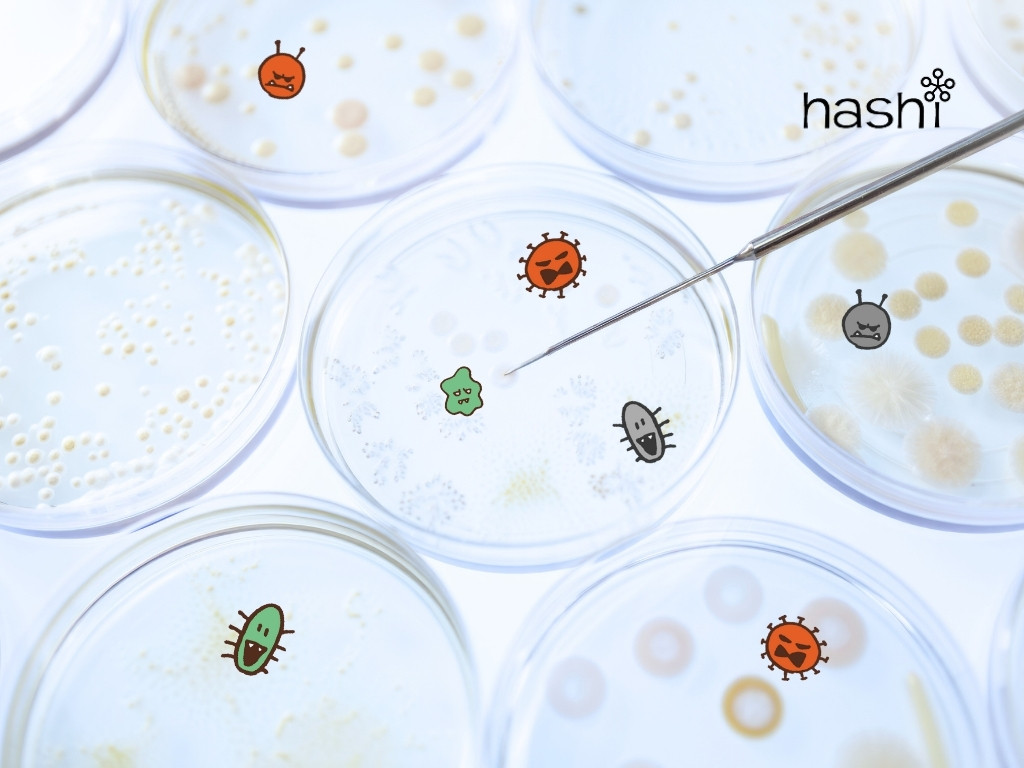
bacteria-2

โลกของเรามีแบคทีเรียนับล้านชนิด บางชนิดเป็นภัยร้ายที่จ้องทำลายสุขภาพ ในขณะที่บางชนิดกลับเป็นมิตรผู้ทรงคุณค่าที่ช่วยให้ร่างกายทำงานได้อย่างปกติ
ดังนั้น บทความนี้เราเลยจะพาคุณไปสำรวจโลกของแบคทีเรียอย่างละเอียด เพื่อทำความเข้าใจว่าสิ่งมีชีวิตนี้คืออะไร พร้อมแนะนำวิธีป้องกันตัวเองจากแบคทีเรียร้ายอย่างถูกวิธี เพื่อให้คุณสามารถใช้ชีวิตได้อย่างมั่นใจในโลกที่เต็มไปด้วยแบคทีเรียตัวจิ๋ว
แบคทีเรีย คืออะไร ?
แบคทีเรีย หรือ bacteria คือ จุลชีพเซลล์เดียวในกลุ่มโพรคาริโอต หมายถึงไม่มีเยื่อหุ้มนิวเคลียส ซึ่งโดยทั่วไปแล้วเซลล์แบคทีเรียมีส่วนประกอบหลัก 2 ส่วน คือ
1. ส่วนผนังเซลล์และเยื่อหุ้มเซลล์
ผนังเซลล์ที่อยู่ชั้นนอกสุดมีความแข็งแรงมาก ทำหน้าที่เหมือนโครงกระดูก ที่ช่วยรักษารูปร่างของแบคทีเรียไว้ อย่างไรก็ตาม โครงสร้างของผนังเซลล์จะแตกต่างกันไปตามสปีชีส์
ถัดมา คือ เยื่อหุ้มเซลล์บางๆ ทำหน้าที่สำคัญในการควบคุมการแลกเปลี่ยนสารอาหารและน้ำ ระหว่างภายในและภายนอกเซลล์ เพื่อการดำรงชีวิตที่เหมาะสม
2. ส่วนไซโทพลาซึม
อยู่ถัดจากเยื่อหุ้มเซลล์ ภายในบรรจุสารอาหาร (เช่น แป้ง ไขมัน), โปรตีน, เอนไซม์ที่จำเป็นต่อการดำรงชีวิต และที่สำคัญที่สุด คือ กรดนิวคลีอิกหรือดีเอ็นเอ ซึ่งเป็นรหัสพันธุกรรมสำหรับควบคุมการดำรงชีวิตและการสืบพันธุ์ของแบคทีเรียแต่ละสายพันธุ์
นอกจากนี้ แบคทีเรียบางชนิดยังสามารถสร้างผนังที่หนาเป็นพิเศษล้อมรอบตัวเอง เรียกว่า สปอร์หรือแคปซูล ซึ่งทำให้มันทนทานต่อความร้อน, ความเย็น ความชื้นได้สูงมาก และสามารถอยู่รอดได้นานหลายปีแม้ในสภาวะที่ขาดแคลนอาหาร

แบคทีเรีย มีกี่ชนิด ?
✅ แบ่งตามการย้อมติดสี : การย้อมติดสีแบบแกรม (Gram staining) เป็นวิธีที่นิยมใช้และมีความสำคัญในการจำแนกแบคทีเรียออกเป็น 2 กลุ่มหลัก โดยอาศัยความแตกต่างของผนังเซลล์ ดังนี้
เมื่อหยดสีย้อมแกรมซึ่งเป็นสีน้ำชนิดหนึ่งลงไป แบคทีเรียแกรมบวก (Gram positive) จะมีผนังเซลล์ติดสีน้ำเงิน ในขณะที่ แบคทีเรียแกรมลบ (Gram negative) จะมีผนังเซลล์ติดสีแดง
✅ แบ่งตามรูปร่าง : การแบ่งประเภทของแบคทีเรียตามลักษณะรูปร่าง จะแบ่งออกเป็น 3 กลุ่ม ดังนี้
- รูปร่างกลม (Coccus) เช่น Staphylococcus spp. ที่อาจอยู่รวมกันเป็นกลุ่ม หรือ Streptococcus spp. ที่เรียงตัวต่อกันเป็นสาย
- รูปร่างเป็นแท่ง (Bacillus) เช่น Bacillus anthracis ที่มีลักษณะเป็นแท่งยาวและหนาเรียงกันเป็นเส้นตรง
- รูปร่างเป็นเกลียว (Spirochete) เช่น Leptospira interrogans ที่มีลักษณะเป็นเส้นยาว หนา และบิดเป็นเกลียว
✅ แบ่งตามการใช้ออกซิเจน : การแบ่งแบคทีเรียโดยใช้เกณฑ์เรื่องการใช้อากาศ หรือไม่ใช้อากาศในการดำรงชีวิต จะแบ่งออกเป็น 3 กลุ่ม ดังนี้
- กลุ่มแอโรบส์ (Aerobe) จำเป็นต้องใช้ออกซิเจนในการสร้างพลังงานเพื่อดำรงชีวิต โดยส่วนใหญ่แบคทีเรียจะจัดอยู่ในกลุ่มนี้
- กลุ่มแอนแอโรบส์ (Anaerobe) ไม่ต้องการออกซิเจนและมักจะตายเมื่อสัมผัสกับอากาศ จึงพบได้ตามบริเวณที่มีออกซิเจนน้อย เช่น ในช่องท้องหรือปาก และแบคทีเรียกลุ่มนี้มักสร้างปัญหาในการติดเชื้อเนื่องจากมีการเจริญเติบโตเร็วและดื้อต่อยาต้านจุลชีพ
- กลุ่มฟาคัลเททีพ (Facultative) สามารถดำรงชีวิตได้ทั้งในสภาพที่มีและไม่มีออกซิเจน ยกตัวอย่างเช่น Escherichia coli หรือ อีโคไล (E. coli) ที่พบในลำไส้ใหญ่ของมนุษย์

แบคทีเรียและการส่งผลต่อระบบทางเดินหายใจ
แบคทีเรียส่วนใหญ่มักมีประโยชน์หรือเป็นกลางต่อร่างกาย แต่แบคทีเรียก่อโรคส่วนน้อยนิดกลับมีกลไกการบุกรุกและเอาตัวรอดที่ซับซ้อน
พวกมันสามารถปรับตัวเพื่อหลบเลี่ยงระบบภูมิคุ้มกันและสร้างปัจจัยความรุนแรง เช่น สารพิษและเอนไซม์ทำลายเนื้อเยื่อ นอกจากนี้ ยังสามารถสร้างชั้นชีวภาพเพื่อยึดเกาะและป้องกันตัวเองได้ด้วย ดังนั้น การทำความเข้าใจกลยุทธ์การบุกรุกเหล่านี้ จึงเป็นสิ่งสำคัญยิ่งในการต่อสู้กับโรคติดเชื้อที่แพร่กระจายไปตามระบบอวัยวะสำคัญต่างๆ ของร่างกาย
🦠 แบคทีเรียกับระบบทางเดินหายใจ
แบคทีเรียในระบบทางเดินหายใจ มีดังนี้
- Streptococcus pneumoniae แกรม+ มีรูปร่างลักษณะกลม
- Streptococcus pyogenes (Group A Streptococcus) แกรม+ มีรูปร่างกลม
- Haemophilus influenzae แกรม- มีรูปร่างเป็นแท่ง
- Moraxella catarrhalis แกรม- มีรูปร่างกลม
- Mycoplasma pneumoniae ไม่มีผนังเซลล์ รูปร่างไม่แน่นอน (มีทั้งกลม แท่ง เกลียว)
- Mycobacterium tuberculosis แกรม+ รูปร่างเป็นแท่ง
- Corynebacterium diphtheriae แกรม+ มีรูปร่างเป็นแท่ง
- Pseudomonas aeruginosa แกรม- มีรูปร่างเป็นแท่ง
[ตัวอย่าง]
🦠 ชนิดของโรคที่เกิดจากแบคทีเรีย Streptococcus pneumoniae
เชื้อนิวโมคอคคัส (Pneumococcus) หรืออีกชื่อหนึ่ง คือ Streptococcus pneumoniae เป็นเชื้อที่พบได้ทั่วไปในระบบทางเดินหายใจส่วนต้น (โพรงจมูกและคอหอย) โดยผู้ที่มีเชื้อนิวโมคอคคัสในร่างกายอาจเป็นโรคหรือไม่เป็นโรคก็ได้ อย่างไรก็ตาม หากเชื้อนี้ก่อโรคก็มักเป็นสาเหตุสำคัญที่ทำให้เกิดการติดเชื้อบริเวณดังกล่าว เช่น โรคหูชั้นกลางอักเสบและไซนัสอักเสบ
🦠 อาการของโรคที่เกิดจากแบคทีเรีย Streptococcus pneumoniae
เชื้อนิวโมคอคคัส หรือ Streptococcus pneumoniae เป็นสาเหตุของโรคทางเดินหายใจที่ไม่รุนแรงและพบได้บ่อย เช่น ไซนัสอักเสบ ซึ่งมีอาการ ดังนี้
- คัดหรือแน่นจมูก
- น้ำมูกไหลออกมาทางรูจมูกด้านหน้า หรือไหลลงคอ
- ปวดหรือแน่นบริเวณใบหน้า อาจสูญเสียการรับกลิ่นร่วมด้วย
- เมื่อตรวจดูภายในโพรงจมูก มีการอุดตัน เนื้อเยื่อบวม อาจพบมีริดสีดวงจมูก หรือหนองไหล
🦠 วิธีป้องกันแบคทีเรีย Streptococcus pneumoniae ในไซนัสอักเสบ :

ในกรณีที่ผู้ป่วยมีอาการไซนัสอักเสบที่เกิดจากเชื้อไวรัส การรักษามักมุ่งเน้นไปที่การบรรเทาอาการเพื่อให้ผู้ป่วยรู้สึกสบายขึ้น ได้แก่ การให้ยาแก้ปวดเพื่อลดอาการปวดศีรษะหรือปวดบริเวณใบหน้า การแนะนำให้ล้างจมูกด้วยน้ำเกลือเพื่อช่วยชะล้างน้ำมูกและลดอาการคัดจมูก รวมถึง การใช้ยาคอร์ติโคสเตียรอยด์ชนิดพ่นจมูก เพื่อช่วยลดการอักเสบและอาการบวมภายในโพรงจมูกและไซนัส
| ในกรณีที่ตรวจพบการติดเชื้อแบคทีเรีย นอกเหนือจากการรักษาเบื้องต้นแล้ว ผู้ป่วยจำเป็นต้องได้รับยาปฏิชีวนะเพิ่มเติม (ยาฆ่าเชื้อแบคทีเรีย) รวมถึงการรักษาด้วยการผ่าตัด Functional Endoscopic Sinus Surgery (FESS) ซึ่งจะถูกพิจารณาเป็นลำดับสุดท้าย เมื่อวิธีการรักษาแบบประคับประคองไม่ได้ผล หรือผู้ป่วยมีภาวะริดสีดวงจมูก หรือเริ่มปรากฏอาการแทรกซ้อนที่ส่งผลกระทบต่ออวัยวะสำคัญ เช่น ตาหรือสมอง เช่น อาการสายตาพร่าเลือน อาการปวดศีรษะอย่างรุนแรง หรือการอาเจียนที่เกิดขึ้นบ่อยครั้ง |
อย่างไรก็ตาม การตัดสินใจนี้จะต้องคำนึงถึงปัจจัยสำคัญอื่นๆ ของผู้ป่วยร่วมด้วยเสมอ เช่น อายุ สุขภาพโดยทั่วไป และโรคประจำตัวของผู้ป่วย เพื่อให้การรักษาเหมาะสมที่สุด
คำถามพบบ่อย (FAQ)
| แบคทีเรียดี มีอะไรบ้าง ? | แบคทีเรียดี อาทิ Probiotics Lactobacillus spp. – L. reuteri, L. Casei, L. Acidophilus, L. Bulgaricus, L.brevis, L. Rhamnosus – Saccharomyces boulardii – Enterogermina – Bacillus clausii, Bacillus subtilis – Bifidobacterium spp. – B. Bifidum, Longum, B. Breve, B.infantis – Streptococcus thermophilus |
| โรคอะไรบ้างที่เกิดจากแบคทีเรีย ? | โรคจากติดเชื้อแบคทีเรียที่พบบ่อยในบ้านเรา คือ – อหิวาตกโรค – โรคปอดบวม หรือปอดอักเสบ – โรคไอกรน – โรคบาดทะยัก – โรคฉี่หนู – โรคไทฟอยด์ – วัณโรค – โรคต่อมทอนซิลอักเสบ – โรคหูส่วนกลางอักเสบเป็นหนอง เช่น หูชั้นกลางอักเสบ- เรื้อรัง – โรคไส้ติ่งอักเสบ – โรคหนองใน |
| แบคทีเรีย ทําหน้าที่อะไร ? | แบคทีเรียที่อาศัยอยู่ในร่างกายของเรามีบทบาทสำคัญหลายด้าน แต่โดยหลักๆ แล้วพวกมันจะช่วยในกระบวนการย่อยสลายอาหารที่เราบริโภค ซึ่งช่วยให้ร่างกายสามารถดูดซึมสารอาหารที่จำเป็นได้ นอกจากนี้ แบคทีเรียเหล่านี้ยังทำหน้าที่ในการช่วยลดสารพิษ และป้องกันการเกิดสารพิษในร่างกาย และที่สำคัญ พวกมันยังเป็นเหมือนเกราะป้องกันตามพื้นผิวที่มันอาศัยอยู่ เพื่อป้องกันไม่ให้เชื้อโรคภายนอกเข้ามาบุกรุกและก่อให้เกิดการติดเชื้อได้ |
บทสรุป
จะเห็นได้ว่า การทำความเข้าใจเกี่ยวกับแบคทีเรียอย่างถูกต้องนั้นไม่น่ากลัวอย่างที่คิด แต่กลับเป็นการเพิ่มพูนความรู้ให้แก่คุณ เพื่อให้คุณสามารถดูแลสุขอนามัยของตนเองได้อย่างมีประสิทธิภาพ และป้องกันเชื้อโรคอันตรายต่างๆ ได้อย่างชาญฉลาด ดังนั้น คุณจึงสามารถใช้ชีวิตได้อย่างมั่นคง ปลอดภัย และมีความสุขในโลกที่มีความหลากหลายทางชีวภาพนี้ได้อย่างแท้จริง
ขอบคุณข้อมูลจาก :
HD Mall,
นพ. วรวุฒิ เจริญศิริ ศูนย์ข้อมูลสุขภาพกรุงเทพ,
Bumrungrad Hospital,
HD Mall,
โรงพยาบาลนครธน,
โรงพยาบาลนนทเวช,
หาหมอ,
ReAct,
รองศาสตราจารย์ จุไรรัตน์ นิลกุล ภาควิชาจุลชีววิทยาคลินิกและเทคโนโลยีประยุกต์ คณะเทคนิคการแพทย์ มหาวิทยาลัยมหิดล,
















